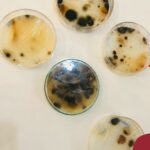

Na quarta-feira, dia 19.06, o Nível 5B, acompanhado pela professora Jéssica e monitora Camila, participou de uma vivência com a turma do 2º ano do Ensino Médio, na eletiva de Imunologia e Saúde pública, orientada pela professora Ângela Lenz, de Biologia. Aprenderam que o ingrediente responsável por deixar o pão macio e fofinho é o fermento. É, mas o mais interessante disso tudo é que o fermento usado no pão, chamado de fermento biológico, é um fungo. Quer dizer, vários fungos. Os fungos do fermento não são grandões como os cogumelos, mas seres microscópicos, que vivem no ar e na superfície das coisas. Ainda na mesma manhã, analisaram os fungos presentes nos espaços da escola a partir da coleta de microrganismos organizada pelos estudantes. A situação faz parte do projeto: “A fantástica descoberta dos cogumelos no pátio”. Um momento significativo para as crianças! A turma agradece aos envolvidos para essa vivência acontecer!